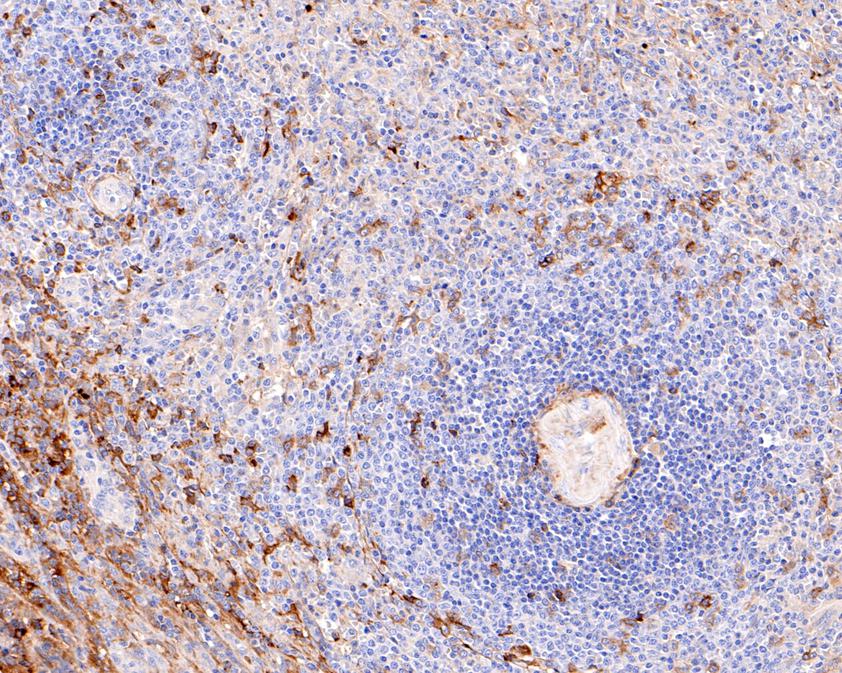

Catalog# ET1703-10
IgA Recombinant Rabbit Monoclonal Antibody [JM10-42]
Application
-
WB
-
IF-Cell
-
IF-Tissue
-
IHC-P
-
IP
Reactivity
-
Human
Conjugation
-
unconjugated

浙公网安备 33019202000643号
浙公网安备 33019202000643号